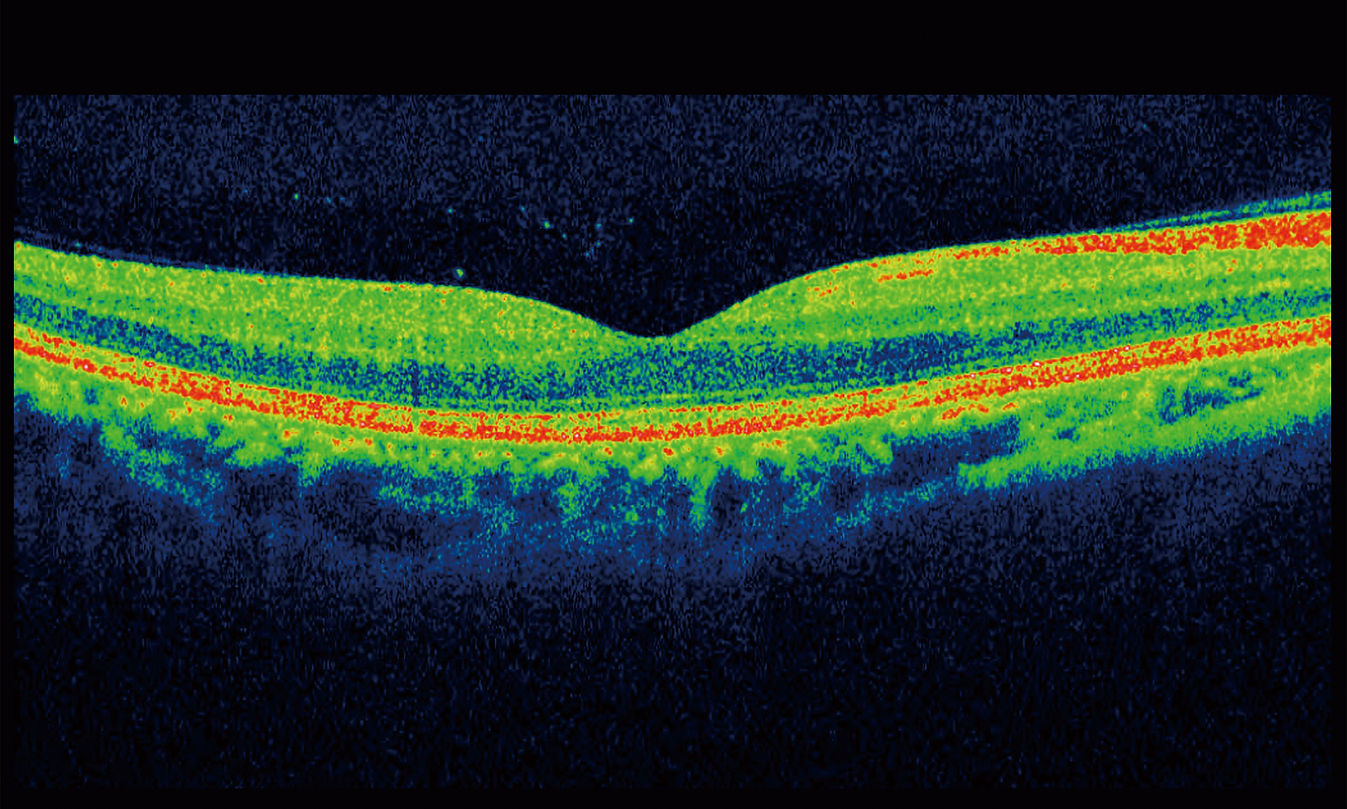

Clínica Oftalmológica
Dr. Lluís Arias Barquet
Especialistas en retina, mácula y cirugía oftalmológica avanzada.
Bienvenidos a nuestra clínica
Es un placer darles la bienvenida a esta página web, desde donde podrán conocer nuestra actividad profesional y las prestaciones asistenciales que ofrecemos en la Clínica Oftalmológica.
Asimismo, los mantendremos informados de las novedades que vayamos aplicando en el diagnóstico y tratamiento de las enfermedades oftalmológicas, así como las últimas publicaciones científicas y vídeos quirúrgicos, mediante nuestras redes sociales.
Esperamos que los contenidos sean de su gusto. Para cualquier duda o sugerencia, no duden en ponerse en contacto con nosotros.
Saludos cordiales,
Equipo Clínica Oftalmológica Dr. Lluís Arias.

Áreas de especialización
El objetivo de la Clínica Oftalmológica es ofrecer un servicio integral dedicado al cuidado de la salud ocular, abarcando tanto el diagnóstico como el tratamiento de las principales patologías visuales.
Gracias a nuestro compromiso con la excelencia médica y al uso de tecnología de última generación, nuestros pacientes reciben una atención cercana, personalizada y de la más alta calidad.
-
La mácula es la zona central de la retina responsable de la visión fina y detallada. En nuestra clínica realizamos diagnóstico y tratamiento de enfermedades maculares como la degeneración macular asociada a la edad, utilizando tecnología de alta precisión para preservar la mejor calidad visual.
-
La retina transforma la luz en imágenes. Contamos con experiencia en patologías retinianas como desprendimientos, oclusiones vasculares o retinopatías, ofreciendo un abordaje integral con pruebas avanzadas y tratamientos especializados.
-
La catarata es una pérdida de transparencia del cristalino que afecta la visión con los años. Ofrecemos evaluación y cirugía de cataratas mediante técnicas modernas y lentes intraoculares de última generación, buscando siempre una recuperación visual óptima y personalizada.
-
La miopía es un defecto refractivo que provoca dificultad para ver de lejos. Además de su corrección con gafas o lentes de contacto, realizamos estudios para el control de la miopía en niños y adultos y evaluaciones para posibles tratamientos quirúrgicos cuando están indicados.
-
El glaucoma es una enfermedad del nervio óptico que puede causar pérdida de visión progresiva. Realizamos controles exhaustivos, pruebas diagnósticas y tratamientos médicos o quirúrgicos según las necesidades de cada paciente, con el objetivo de proteger su visión a largo plazo.

Nuestros servicios
Pruebas
Realizamos pruebas avanzadas para evaluar la salud visual y detectar cualquier alteración ocular. Utilizamos tecnología de alta precisión para estudiar la graduación, la retina, el campo visual, la córnea y otros elementos clave del ojo, garantizando diagnósticos completos y fiables.

Tratamientos de enfermedades oculares
Ofrecemos tratamientos personalizados para diversas enfermedades oculares, desde problemas retinianos hasta alteraciones palpebrales o de la superficie ocular. Aplicamos técnicas modernas, como láser, microcirugía e inyecciones intraoculares, para asegurar una atención eficaz y adaptada a cada paciente.
Conoce a nuestro equipo

Dr. Lluís Arias Barquet
Licenciado en Medicina y Cirugía por la Universidad de Barcelona (1992). Especialidad de oftalmología vía MIR en el Hospital Universitario de Bellvitge (1994 - 1997).
Doctorado por la Universidad Autónoma de Barcelona (2007) con la calificación de sobresaliente cum laude. Premio extraordinario de doctorado.
Jefe de sección de Retina del servicio de Oftalmología del Hospital Universitario de Bellvitge.
Profesor agregado de la Facultad de Medicina de la Universidad de Barcelona.
Investigador principal en numerosos ensayos clínicos nacionales e internacionales. Principales áreas de interés: degeneración macular asociada a la edad, miopía, retinopatía diabética, cirugía de cataratas y cirugía de retina y vítreo.
Miembro de American Academy of Ophthalmology, European Society of Retina Specialists (Euretina), Sociedad Española de Retina y Vítreo, Sociedad Española de Oftalmología y Sociedad Catalana de Oftalmología.

Dra. Mª Teresa García Rodríguez
Licenciada en Medicina y Cirugía por la Universidad de Barcelona (1992). Especialidad de Diagnóstico por la Imagen vía MIR en el Hospital de la Santa Creu i Sant Pau (1993 - 1996).

Sonia Moreno Martínez
Auxiliar administrativa con quince años de experiencia en consulta médica.

Marta Carbonell Puerto
Auxiliar administrativa con veinte años de experiencia en consulta médica.
Síguenos en redes
Sigue las novedades de nuestra clínica en redes sociales: y acompaña al Dr. Lluís Arias en congresos y eventos, y conoce nuestra actividad profesional. ¡Te esperamos!










Contacta con nosotros
Si tienes dudas o quieres más información sobre nuestros servicios, contáctanos mediante este formulario. Nuestro equipo te atenderá con gusto lo antes posible. Tu bienestar visual es nuestra prioridad.




